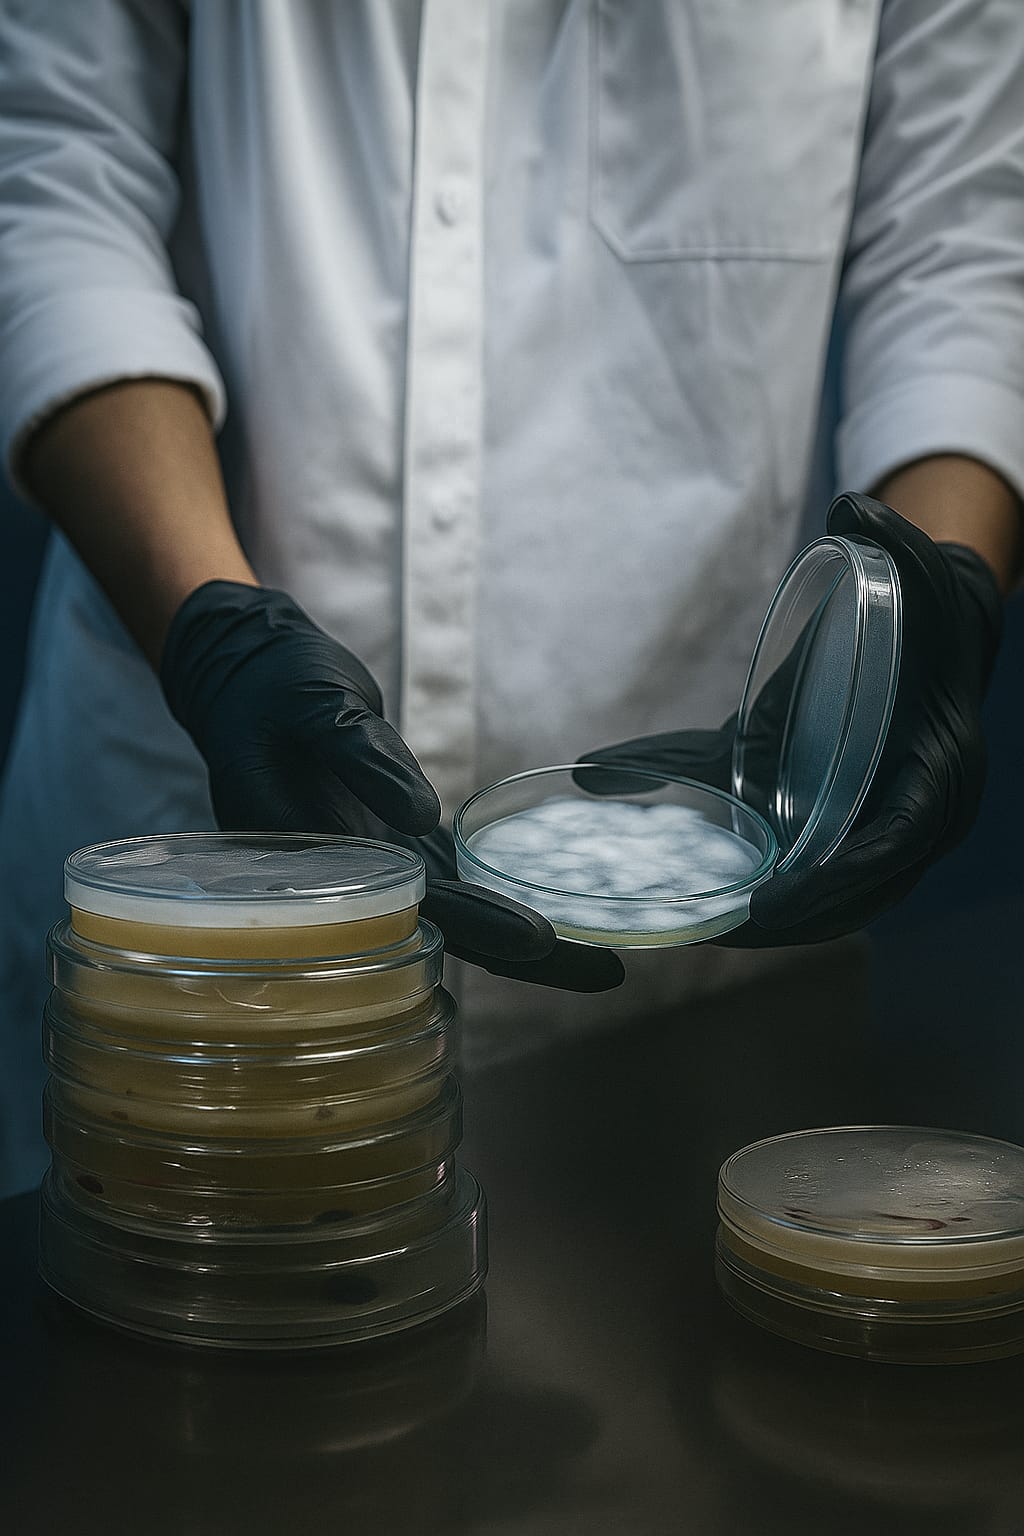

Transformar la biotecnología mexicana en oportunidades. Desarrollamos y ofrecemos productos, insumos y cepas exclusivas para impulsar el cultivo de hongos comestibles y medicinales, desde la inoculación a tu hogar, con innovación y sostenibilidad
Ser líderes en la fungicultura y biotecnología aplicada en México, reconocidos por la calidad de nuestros productos de valor agregado, la innovación en el manejo de cepas, y nuestro compromiso con el medio ambiente y la agricultura sustentable.
- Innovación Constante: Ciencia de vanguardia para tu cultivo.
- Sostenibilidad Real: Crecemos con el planeta.
- Asesoría Experta: Tu éxito es nuestro crecimiento.
- Orgullo Mexicano: Biotecnología desde casa para el mundo.
Productos recomendados
Su snippet dinámico aparecerá aquí... Este mensaje aparece porque no proporcionó ni el filtro ni la plantilla a usar.
Productos recomendados
Su snippet dinámico aparecerá aquí... Este mensaje aparece porque no proporcionó ni el filtro ni la plantilla a usar.